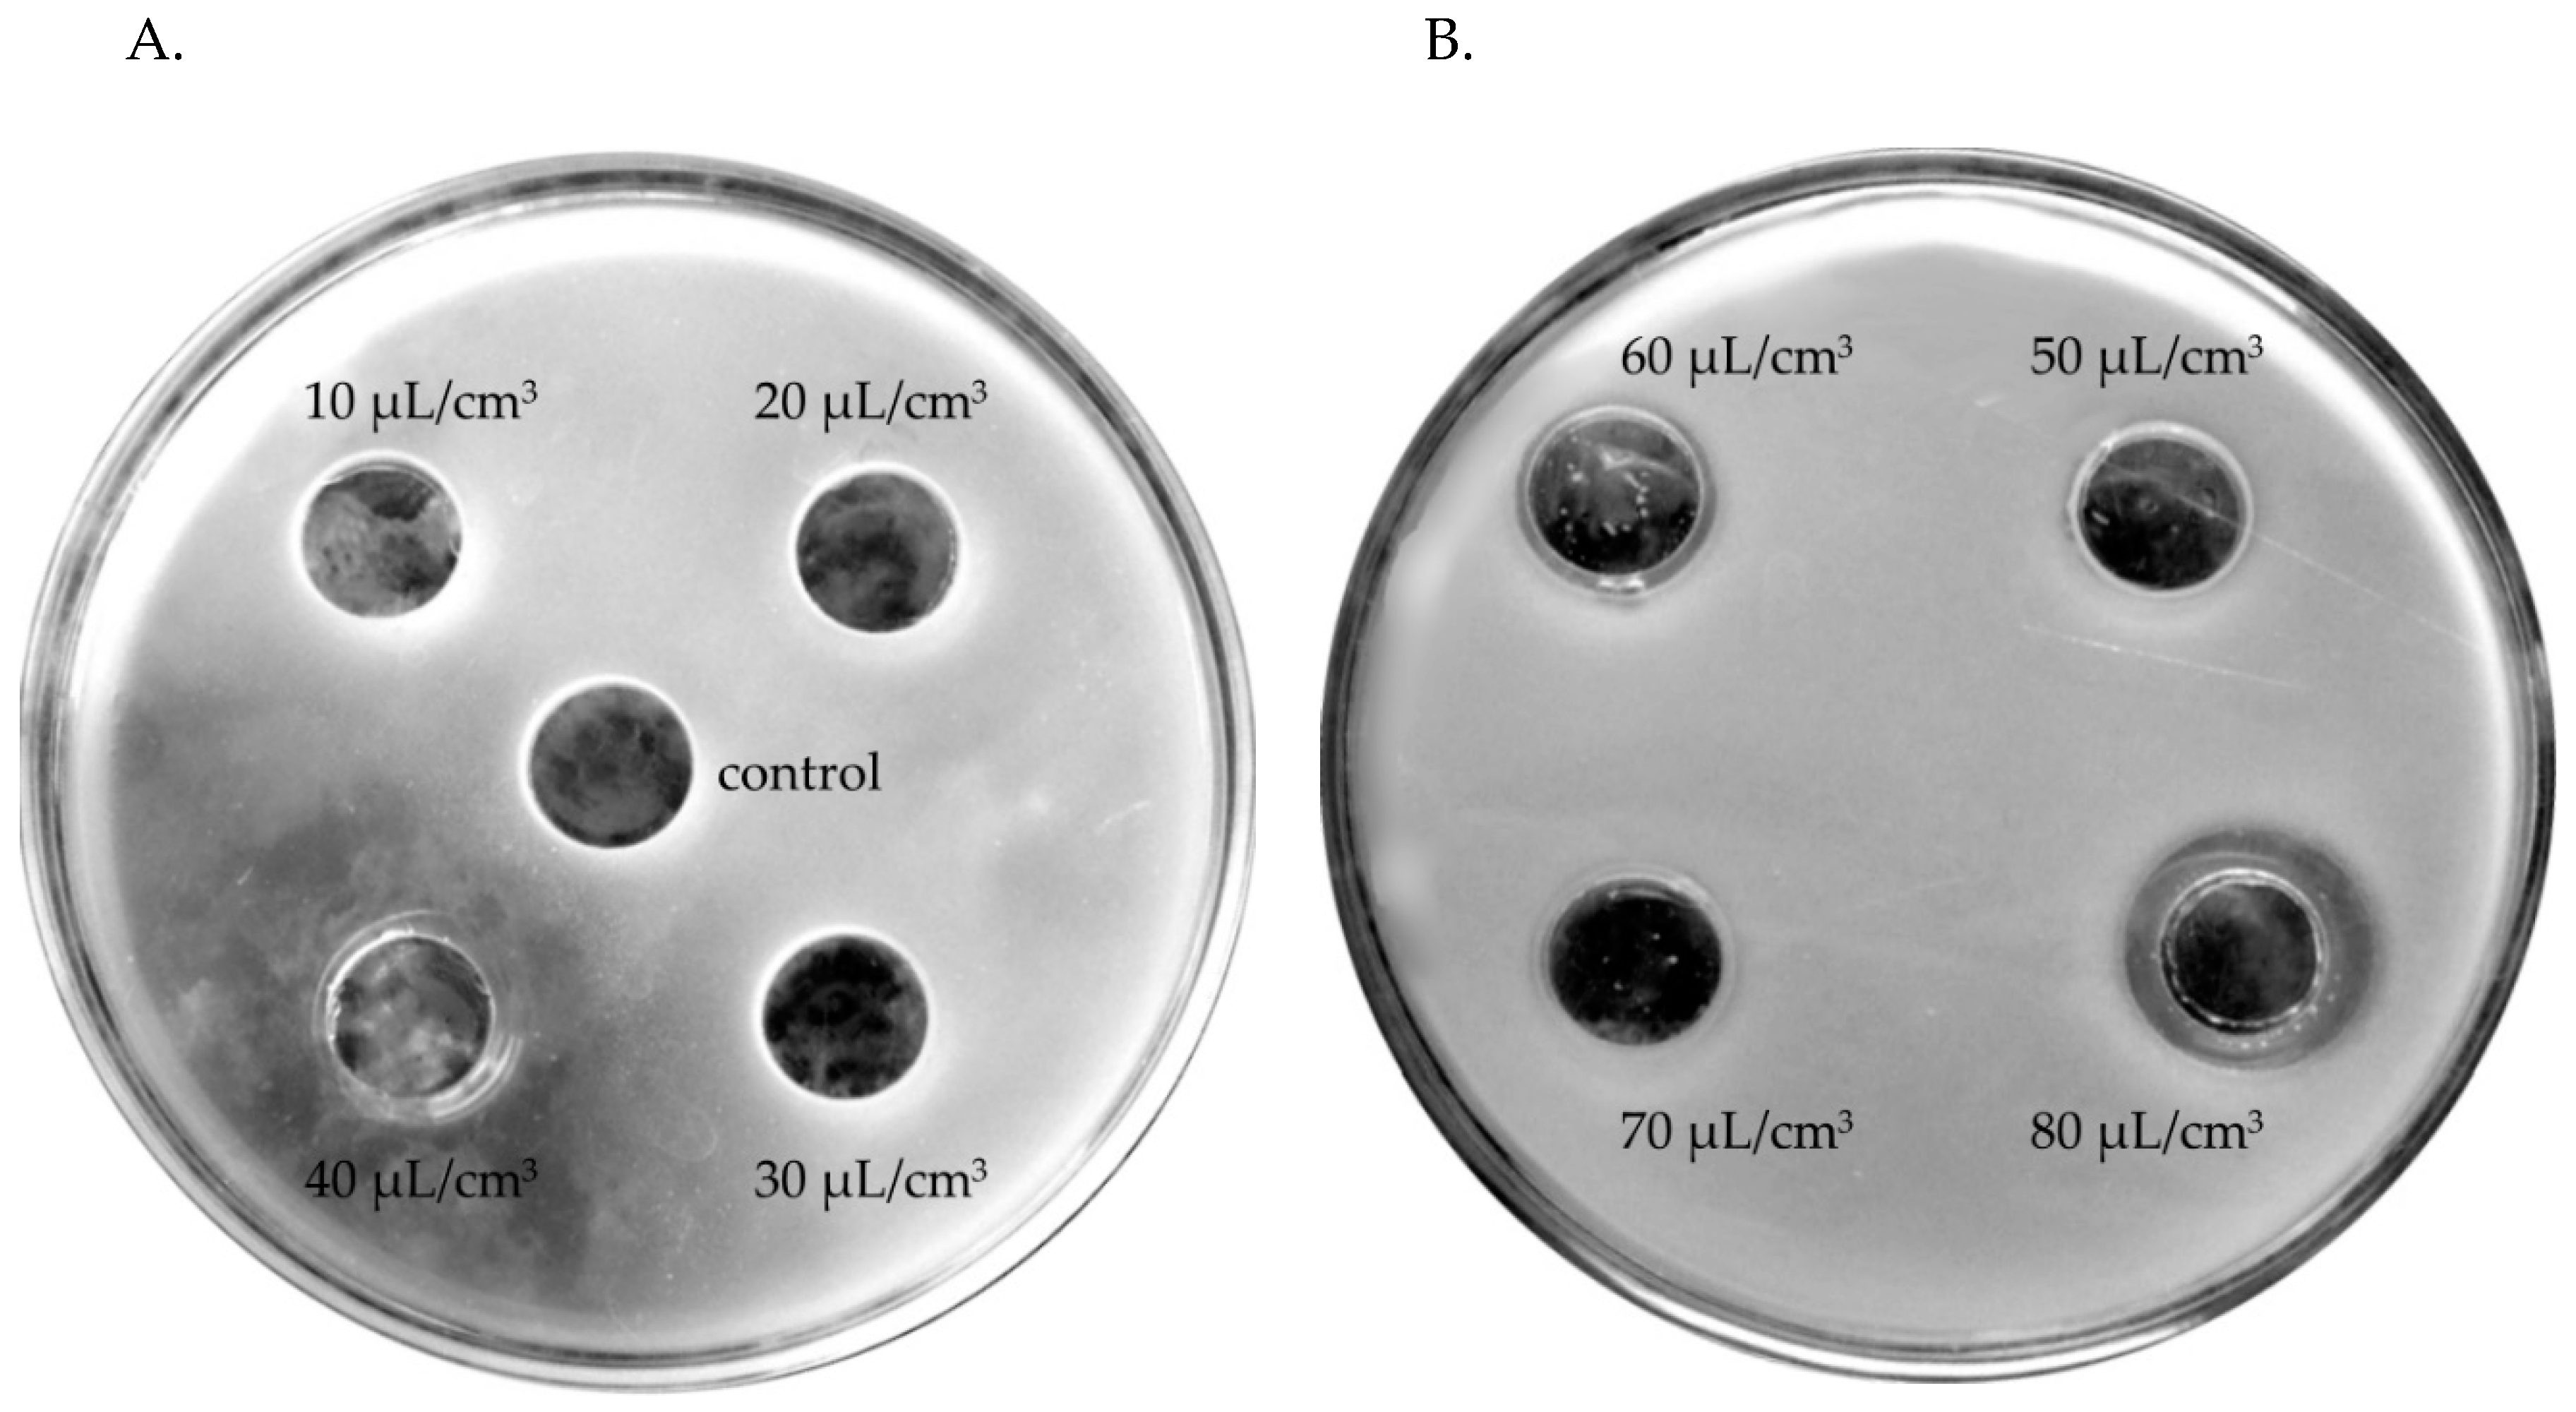
Molecules 24 03270 g003

Chemical Composition of Two Different Lavender Essential Oils and Their Effect on Facial Skin Microbiota
Abstract
:1. Introduction
- Narrow-leaved lavender (real, medical) Lavandula officinalis Chaix, syn. L. vera DC, L. angustifolia Mill.;
- Broad-leaved lavender (spike lavender) Lavandula latifolia Vill. (Syn. L. spica DC);
- Lavandin, a hybrid of the two preceding species.
2. Results
2.1. Chemical Analysis
2.2. Biological Analysis
3. Discussion
4. Materials and Methods
4.1. Materials
4.2. Gas Chromatography with Mass Spectrometry (GC–MS)
4.3. Biological Experiment
5. Conclusions
Author Contributions
Funding
Conflicts of Interest
References
- Jabłońska-Trypuć, A.; Farbiszewski, R. Sensory and Basics of Perfumery; MedPharm: Wroclaw, Poland, 2008; pp. 114–115, 121–129. [Google Scholar]
- Lazzara, M.V. Aromatherapy. Healing Baths; Bauer-Weltbild Media Sp. z.o.o.: Warszawa, Poland, 2003; pp. 19–29. [Google Scholar]
- Góra, J.; Lis, A. The Most Valuable Essential Oils; UMK Publishing: Torun, Poland, 2005; pp. 165–175. [Google Scholar]
- Góra, J.; Lis, A. The most valuable oils–Lavender oil. Aromaterapia PTA 1995, 2, 5–11. [Google Scholar]
- Glinka, R.; Glinka, M. Cosmetic Recipe with Elements of Cosmetology; MA Publishing: Lodz, Poland, 2008; pp. 70–73. [Google Scholar]
- Janeczko, Z.; Pisulewska, E. Domestic Oil Plants. Occurrence, Cultivation, Chemical Composition, Application; “Know-How” Publishing: Kraków, Poland, 2008; pp. 7–11, 43–47. [Google Scholar]
- Da Porto, C.; Decorti, D.; Kikc, I. Flavour compounds of Lavandula angustifolia L. to use in food manufacturing: Comparison of three different extraction methods. Food Chem. 2009, 112, 1072–1078. [Google Scholar] [CrossRef]
- Danh, L.T.; Han, L.N.; Triet, N.D.A.; Zhao, J.; Mammucari, R.; Foster, N. Comparison of chemical composition, antioxidant and antimicrobial activity of lavender (Lavandula angustifolia L.) Essential oils extracted by supercritical CO2, hexane and hydrodistillation. Food Bioprocess Technol. 2013, 6, 3481–3489. [Google Scholar] [CrossRef]
- Reverchon, E.; Della Porta, G. Supercritical CO2 extraction and fractionation of Lavender essential oil and waxes. J. Agric. Food Chem. 1995, 43, 1654–1658. [Google Scholar] [CrossRef]
- Mantovani, A.L.L.; Vieira, G.P.G.; Cunha, W.R.; Groppo, M.; Santos, R.A.; Rodrigues, V.; Magalhăes, L.G.; Crotti, A.E.M. Chemical composition, antischistosomal and cytotoxic effects of the essential oil of Lavandula angustifolia grown in Southeastern Brazil. Rev. Bras. Farmacogn. 2013, 23, 877–884. [Google Scholar] [CrossRef]
- Steltenkamp, R.J.; Casazza, W.T. Composition of the essential oil of Lavandin. J. Agric. Food Chem. 1967, 15, 1063–1069. [Google Scholar] [CrossRef]
- Dob, T.; Dahmane, D.; Berramdane, T.; Chelghoum, C. Chemical composition of the essential oil of Lavandula dentata L. from Algeria. Int. J. Aromather. 2005, 15, 110–114. [Google Scholar] [CrossRef]
- Shellie, R.; Mondello, L.; Marriott, P.; Dugo, G. Characterisation of lavender essential oils by using gas chromatography-mass spectrometry with correlation of linear retention indices and comparison with comprehensive two-dimensional gas chromatography. J. Chromatogr. A. 2002, 970, 225–234. [Google Scholar] [CrossRef]
- Cong, Y.; Abulizi, P.; Zhi, L.; Wang, X. Chemical composition of the essential oil of Lavandula angustifolia from Xinjiang, China. Chem. Nat. Compd. 2008, 44, 810–815. [Google Scholar] [CrossRef]
- Daferera, D.J.; Ziogas, B.N.; Polissou, M.G. GC-MS analysis of essential oils from some Greek aromatic plants and their fungitoxicity on Penicillium digitatum. J. Agric. Food Chem. 2000, 48, 2576–2581. [Google Scholar] [CrossRef]
- Yazdani, E.; Sendi, J.J.; Aliakbar, A.; Senthil-Nathan, S. Effect of Lavandula angustifolia essential oil against lesser mulberry pyralid Glyphodes pyloalis Walker (Lep: Pyralidae) and identification of its major derivatives. Pest. Bioch. Physiol. 2013, 107, 250–257. [Google Scholar] [CrossRef]
- Dadalioglu, I.; Evrendilek, G.A. Chemical compositions and antibacterial effects of essential oils of Turkish Oregano (Origanum minutiflorum), Bay Laurel (Laurus nobilis), Spanish Lavender (Lavandula stoechas L.), and Fennel (Foeniculum vulgare) on common foodborne pathogens. J. Agric. Food Chem. 2004, 52, 8255–8260. [Google Scholar] [CrossRef] [PubMed]
- Hassiotis, C.N. Chemical compounds and essential oil release through decomposition process from Lavandula stoechas in Mediterranean region. Biochem. Sys. Ecol. 2010, 38, 493–501. [Google Scholar] [CrossRef]
- Hanamanthagouda, M.S.; Kakkalameli, S.B.; Naik, P.M.; Nagella, P.; Seetharamareddy, H.R.; Murthy, H.N. Essential oils of Lavandula bipinnata and their antimicrobial activities. Food Chem. 2010, 118, 836–839. [Google Scholar] [CrossRef]
- Kulkarni, R.R.; Pawar, P.V.; Joseph, M.P.; Akulwad, A.K.; Sen, A.; Joshi, S.P. Lavandula gibsoni and Plectranthus mollis essential oils: Chemical analysis and insect control activities against Aedes aegypti, Anopheles stephensi and Culex quinquefasciatus. J. Pest. Sci. 2013, 86, 713–718. [Google Scholar] [CrossRef]
- Palá-Paúl, J.; Brophy, J.J.; Goldsack, R.J.; Fontaniella, B. Analysis of the volatile components of Lavandula canariensis (L.) Mill., a Canary Islands endemic species, growing in Australia. Biochem. Sys. Ecol. 2004, 32, 55–62. [Google Scholar] [CrossRef]
- Zuzarte, M.; Vale-Silva, L.; Gonçalves, M.J.; Cavaleiro, C.; Vaz, S.; Canhoto, J.; Pinto, E.; Salgueiro, L. Antifungal activity of phenolic-rich Lavandula multifida L. essential oil. Eur. J. Clin. Microbiol. Infect. Dis. 2012, 31, 1359–1366. [Google Scholar] [CrossRef]
- Białoń, M.; Krzyśko-Łupicka, T.; Pik, A.; Wieczorek, P.P. Chemical composition of herbal macerates and corresponding commercial essential oils and their effect on bacteria Escherichia coli. Molecules 2017, 22, 1887. [Google Scholar] [CrossRef]
- Białoń, M.; Krzyśko-Łupicka, T.; Koszałkowska, M.; Wieczorek, P.P. The influence of chemical composition of commercial lemon essential oils on the growth of Candida strains. Mycopathologia 2014, 177, 29–39. [Google Scholar] [CrossRef]
- Adaszyńska-Skwirzyńska, M.; Swarcewicz, M. Chemical composition and biological activity of medical lavender. Wiad. Chem. 2014, 68, 11–12. [Google Scholar]
- Król, S.K.; Skalicka-Woźniak, K.; Kandefer-Szerszeń, M.; Stepulak, A. The biological and pharmacological activity of essential oils in the treatment and prevention of infectious diseases. Postepy Higieny Medycyny Doswiadczalnej 2013, 67, 1000–1007. [Google Scholar]
- Martini, M.C. Cosmetology and Pharmacology of the Skin; PZWL Publishing: Warszawa, Poland, 2007; pp. 37–44, 52, 105–112, 122. [Google Scholar]
- Grzybowski, J.; Zaborowski, P. Theoretical and Practical Basis of Infectology; Institute of Health Protection Problems, Borgis Publishing: Warszawa, Poland, 2007; pp. 34–55. [Google Scholar]
- Szewczyk, E.M.; Dudkiewicz, B.; Lisiecki, P.; Różalska, M.; Sobiś-Glinkowska, M.; Szarapińska-Kwaszewska, J. Bacteriological Diagnosis; PWN Publishing: Warszawa, Poland, 2005; pp. 11–159, 205–207, 297–342. [Google Scholar]
- Brud, W.; Konopacka-Brud, I. Essential oils as active substances in cosmetics. Herb. Messages 1998, 7/8, 8–10. [Google Scholar]
- Jaroszewska, B. Cosmetology; Atena Publishing: Warszawa, Poland, 2004; pp. 93–94. [Google Scholar]
- Peters, B.; Kerkhoff, E.; Kuska, S.; Schweig, W.; Wulfhorst, B. Cosmetology; Stam REA Publishing: Warszawa, Poland, 2006; pp. 42–43, 233. [Google Scholar]
- Cavanagh, H.M.A.; Wilkinson, J.M. Lavender essential oil: Review. Austr. Infect. Contr. 2005, 10, 35–37. [Google Scholar] [CrossRef]
- Sienkiewicz, M.; Denys, P.; Kowalczyk, E. Antibacterial and immunostimulatory effect of essential oils. Int. Rev. Allergol. Clin. Immunol. 2011, 17, 40–44. [Google Scholar]
- Boelens, M.H. Chemical and sensory evaluation of Lavandula oils. Perf. Flav. 1995, 20, 23–51. [Google Scholar]
- Adaszyńska, M.; Swarcewicz, M.; Markowska-Szczupak, A. Comparison of chemical composition and antimicrobial activity of Lavender varieties from Poland. Post. Fitoter. 2013, 2, 90–96. [Google Scholar]
- Gören, A.C.; Topçu, G.; Bilsel, G.; Bilsel, M.; Aydoğmuş, Z.; Pezzuto, J.M. The chemical constituents and biological activity of essential oil of Lavandula stoechas ssp. stoechas. Zeitschrift Für Naturforschung C 2002, 15, 797–800. [Google Scholar] [CrossRef] [PubMed]
- Sabara, D.; Kunicka-Styczyńska, A. Lavender oil–Flavouring or active cosmetic ingredient? Food Chem. Biotechnol. 2009, 73, 37–42. [Google Scholar]
- Roller, S.; Ernest, N.; Buckle, J. The antimicrobial activity of high-necrodane and other lavender oils on methicillin-sensitive and -resistant Staphylococcus aureus (MSSA and MRSA). J. Altern. Complement. Med. 2009, 15, 275–279. [Google Scholar] [CrossRef]
- Kalemba, D. Antibacterial and antifungal properties of essential oils. Post. Mikrobiol. 1998, 38, 185–203. [Google Scholar] [CrossRef]
- Trytek, M.; Paduch, R.; Fiedurek, J.; Kandefer-Szerszeń, M. Monoterpenes–Old compounds, new applications, and biotechnological methods of their production. Biotechnologia 2007, 76, 135–155. [Google Scholar]
- Grabowska, K.; Janeczko, Z. Essential oils with antiviral activity. Aromaterapia PTA 2009, 58, 9–20. [Google Scholar]
- Johnson, O.O.; Ayoola, G.A.; Adenipekun, T. Antimicrobial activity and the chemical composition of the volatile oil blend from Allium sativum (Garlic Clove) and Citrus reticulate (Tangerine fruit). Int. J. Pharm. Sci. Drug Res. 2013, 5, 187–193. [Google Scholar]
Sample Availability: Samples of the compounds are not available from the authors. |

| Name | Lavandula angustifolia—Place and Area (%) | ||||||||
|---|---|---|---|---|---|---|---|---|---|
| Italy | Australia | China | Greece | Brazil | Iran | ||||
| (a) | (b) | (c) | (a) | (b) | (a) | ||||
| tricyclene | - | 0.02–0.04 | - | - | - | - | - | ||
| α-thujene | 0.13 | 0.11 | 0.05 | 0.02–0.17 | - | - | - | - | - |
| α-pinene | 0.51 | 0.93 | 0.26 | 0.08–0.73 | - | - | - | 0.70 | 1.41 |
| camphene | 0.26 | 0.59 | 0.19 | 0.02–0.54 | 0.19 | 3.98 | - | 0.50 | - |
| β-phellandrene | - | - | - | 0.02–0.11 | - | - | - | 3.40 | - |
| β-pinene | 0.14 | 0.30 | 1.58 | 0.03–1.21 | - | - | - | 1.10 | 1.52 |
| octen-3-ol | 0.22 | 0.20 | 0.16 | 0.03–1.14 | 0.28 | 0.35 | - | - | - |
| 3-octanone | 0.36 | 0.68 | - | 0.33–3.49 | - | - | - | - | - |
| myrcene | 0.12 | - | trace | 0.26–1.22 | 0.56 | 0.87 | - | 0.70 | 1.02 |
| 3-carene | - | - | - | 0.05–0.30 | - | 0.45 | - | 0.90 | 0.76 |
| sabinene | 0.31 | 0.75 | 0.31 | 0.04–0.39 | - | - | - | - | - |
| p-cymene | 0.29 | 0.20 | - | 0.10–0.45 | - | - | - | - | - |
| o-cymene | 0.04 | 0.09 | 0.30 | 0.03–0.12 | - | - | - | - | - |
| limonene | 1.10 | 2.36 | - | 0.18–3.92 | 0.24 | 0.19 | - | - | - |
| eucalyptol | 3.98 | 10.89 | 6.75 | 0.1–10.87 | 1.51 | 2.30 | 4.80 | 7.90 | 3.93 |
| (E)-β-ocimene | 1.24 | 0.42 | 0.56 | 0.34–2.36 | 0.09 | 0.52 | - | - | - |
| (Z)-β-ocimene | 1.02 | 1.32 | 0.77 | 0.95–6.17 | 0.44 | - | - | - | |
| trans-linalool oxide | - | 0.07 | 1.57 | 0.26–0.99 | - | - | - | - | - |
| cis-linalool oxide | 0.09 | 0.07 | 1.48 | 0.34–1.09 | 0.24 | - | - | - | 1.67 |
| trans-sabinene hydrate | 0.39 | 0.34 | - | 0.04–0.20 | - | - | - | - | - |
| linalool | 35.96 | 36.51 | 35.31 | 23.03–57.48 | 52.59 | 44.54 | 44.50 | - | 4.91 |
| cis-p-menth-2-en-1-ol | - | - | - | 0.02–0.04 | - | - | - | - | - |
| trans-pinocarveol | 0.18 | 0.10 | - | 0.01–0.34 | - | - | - | - | - |
| camphor | 5.56 | 11.76 | 7.81 | 0.09–7.10 | 8.79 | - | - | 3.50 | 2.83 |
| myrtenol | - | - | - | 0.04–0.21 | - | - | - | 0.40 | - |
| borneol | 2.71 | 4.21 | 2.98 | 0.30–4.04 | 7.50 | 2.45 | 3.90 | 22.40 | 8.57 |
| p-cymen-8-ol | 0.33 | 0.55 | - | 0.12–0.27 | - | - | - | - | - |
| lavendulol | 0.05 | 0.05 | 0.55 | 0.05–0.86 | - | - | - | - | - |
| terpinen-4-ol | 6.57 | 2.10 | 3.34 | 0.11–8.07 | 2.45 | - | 6.90 | 0.90 | - |
| sabine ketone | - | - | - | 0.02–0.10 | - | - | - | - | - |
| m-cymen-8-ol | 0.03 | 0.09 | - | 0.02–0.18 | - | - | - | - | - |
| α-terpineol | 0.06 | 0.07 | 4.39 | 0.12–6.02 | 3.03 | 6.75 | 3.50 | 1.20 | 1.98 |
| hexyl butyrate | - | - | 0.43 | 0.12–1.72 | - | - | - | - | - |
| isobornyl formate | 0.06 | 0.10 | - | 0.10–0.52 | - | - | - | - | - |
| geraniol | - | - | 0.67 | - | - | 11.02 | - | - | 1.24 |
| cumin aldehyde | - | - | - | 0.04–0.53 | 0.16 | - | - | - | - |
| carvone | - | - | - | 0.02–0.19 | - | - | - | 0.40 | - |
| linalyl acetate | 21.74 | 14.42 | 12.09 | 4.01–35.39 | 9.27 | - | 32.70 | - | - |
| α-bisabolol | 1.12 | 0.89 | 3.76 | 0.02–0.71 | 0.78 | - | - | 13.10 | 2.32 |
| dihydrocarveol | - | - | - | 0.03–0.51 | - | - | - | - | - |
| bornyl acetate | - | - | - | 0.03–0.32 | 1.11 | - | - | - | 1.67 |
| lavendulyl acetate | - | - | - | 0.70–6.16 | 1.32 | 10.78 | - | - | - |
| neryl acetate | 0.06 | - | 1.31 | 0.07–1.23 | 1.21 | - | - | - | 2.16 |
| β-bourbonene | 0.17 | 0.09 | - | 0.02–0.09 | - | - | - | - | - |
| α-trans-bergamotene | 0.07 | 0.05 | - | 0.02–0.15 | 0.07 | - | - | - | - |
| α-cederene | - | - | - | 0.01–0.09 | - | - | - | - | - |
| β-caryophellene | - | - | - | - | - | - | - | 3.20 | 1.60 |
| caryophyllene | 2.87 | 2.42 | 1.30 | 0.45–2.83 | 1.00 | 0.50 | 0.30 | - | - |
| α-santalene | - | - | - | - | 0.05 | - | - | - | - |
| α-cis-bergamotene | 0.07 | 0.06 | - | 0.02–0.09 | - | - | - | - | - |
| β-farnesene | 4.02 | 1.07 | 1.00 | 0.17–1.69 | 1.83 | - | - | - | 0.71 |
| germacene D | 0.77 | 1.50 | - | 0.16–0.94 | 0.37 | - | - | - | - |
| β-bisabolene | 0.03 | - | - | - | 0.26 | - | - | 0.80 | - |
| γ-cadinene | 0.26 | 0.39 | - | 0.03–0.39 | 0.28 | - | - | 2.90 | - |
| caryophyllene oxide | - | - | - | - | 0.22 | - | - | 4.50 | 2.73 |
| spathulenol | 0.06 | 0.31 | - | 0.01–0. 06 | - | - | - | - | - |
| γ-muurolol | - | - | - | 0.02–0.48 | - | - | - | - | - |
| τ-cadinol | - | - | - | 0.02–0.42 | - | - | - | - | 1.85 |
| γ-terpinene | - | - | - | 0.05–0.22 | - | - | - | - | - |
| octen-3-yl acetate | - | - | - | 0.19–4.16 | - | - | - | - | - |
| norborneol acetate | - | - | - | 0.04–0.51 | - | - | - | - | - |
| Name | Place and Area (%) ± SD | ||||||||
|---|---|---|---|---|---|---|---|---|---|
| Lavandin | Lavandula | ||||||||
| abrialis | stoechas | dentata | bipinnata | gibsoni | canarien-sis | multifida | |||
| France | Turkey | Greece | Algeria | India | India | Australia | Portugal | ||
| (b) | (a) | (b) | (c) | (a) | (b) | ||||
| tricyclene | 0.03 | - | 0.20 | 0.40 | - | - | - | - | - |
| α-thujene | - | - | - | trace | - | - | - | - | - |
| α-pinene | 0.40 | 1.31 | 2.52 | trace | 1.01 | 1.47 | trace | 0.80 | 0.60 |
| camphene | 0.30 | 1.40 | 1.30 | - | 0.35 | - | - | - | - |
| β-phellandrene | - | - | 0.10 | - | - | - | - | - | - |
| β-pinene | 0.30 | - | 1.30 | 0.20 | - | - | trace | - | - |
| octen-3-ol | 0.30 | - | - | - | - | 2.20 | - | 0.60 | 0.50 |
| 3-octanone | 1.00 | - | - | - | - | - | - | 0.40 | 0.30 |
| myrcene | 0.30 | - | 0.10 | trace | 0.25 | 2.78 | trace | 5.70 | 5.50 |
| 3-carene | 0.02 | - | - | - | 0.37 | 1.52 | - | 0.50 | 0.50 |
| sabinene | 0.10 | - | - | 1.40 | 0.39 | - | - | - | - |
| p-cymene | 0.04 | - | 4.90 | - | - | 0.82 | trace | 0.30 | 0.20 |
| o-cymene | - | - | - | - | - | - | - | - | - |
| limonene | 0.70 | - | - | - | - | 2.30 | trace | 0.60 | 0.30 |
| eucalyptol | - | 8.03 | 16.30 | 38.40 | - | - | - | - | - |
| (E)-β-ocimene | 2.60 | - | trace | 0.10 | - | trace | trace | 27.40 | 27.00 |
| (Z)-β-ocimene | 3.00 | - | - | - | - | 0.30 | 0.60 | 1.70 | 1.50 |
| trans-linalool oxide | 0.20 | - | - | - | - | - | - | - | - |
| β-citral | - | 0.30 | - | - | |||||
| cis-linalool oxide | 0.1 | - | - | - | - | - | - | - | - |
| trans-sabinene hydrate | - | - | - | 0.10 | - | - | - | - | - |
| linalool | 35.00 | 0.29 | 1.20 | trace | 0.94 | 2.65 | 0.90 | 0.30 | 0.20 |
| cis-p-menth-2-en-1-ol | - | - | - | trace | - | - | - | - | - |
| trans-pinocarveol | - | - | - | - | - | - | - | - | - |
| camphor | 8.90 | 18.18 | 9.90 | 1.60 | 7.09 | - | - | - | - |
| myrtenol | - | - | 1.10 | 1.70 | - | - | - | - | - |
| borneol | 2.90 | - | 0.90 | - | - | - | - | - | - |
| p-cymen-8-ol | - | - | - | 3.80 | - | - | 0.20 | - | - |
| lavandulol | 0.60 | - | 0.40 | - | 0.38 | - | - | - | - |
| terpinen-4-ol | - | - | 0.80 | 0.70 | 0.73 | - | - | - | - |
| sabine ketone | - | - | - | 0.50 | - | - | - | - | - |
| m-cymen-8-ol | - | - | 0.20 | - | - | - | - | - | - |
| α-terpineol | 0.50 | - | 0.50 | 1.80 | - | 0.77 | 0.30 | - | - |
| hexyl butyrate | - | - | - | - | - | - | - | - | - |
| isobornyl formate | - | - | - | - | - | - | - | - | - |
| geraniol | - | - | - | - | - | - | - | - | - |
| cumin aldehyde | - | - | - | 1.10 | - | - | - | - | - |
| carvone | - | - | 0.10 | - | - | - | - | - | - |
| linalyl acetate | 27.00 | - | 0.20 | trace | 3.37 | - | - | - | - |
| α-bisabolol | - | - | trace | - | - | - | 1.50 | 0.20 | 0.20 |
| dihydrocarveol | - | - | - | - | - | - | - | - | - |
| bornyl acetate | - | 1.32 | trace | - | 0.21 | - | - | - | - |
| lavendulyl acetate | 1.00 | - | 3.21 | - | 1.79 | - | - | - | - |
| verbenone | - | - | 0.60 | 0.40 | - | - | - | - | - |
| neryl acetate | 0.70 | - | - | - | - | - | - | - | - |
| β-bourbonene | - | - | - | trace | - | - | trace | - | - |
| α-trans-bergamotene | - | - | - | trace | - | - | - | - | - |
| α-cederene | - | - | - | trace | - | - | - | - | - |
| β-caryophellene | - | - | - | - | 0.18 | - | 7.60 | 0.80 | 0.90 |
| caryophyllene | 0.70 | - | - | 0.50 | - | trace | - | - | - |
| α-santalene | 0.20 | - | - | - | - | - | - | - | - |
| α-cis-bergamotene | - | - | - | - | - | - | - | - | - |
| β-farnesene | 0.30 | - | - | - | - | - | 0.30 | trace | 0.10 |
| germacene D | - | - | 0.10 | - | 1.66 | - | 2.20 | 0.50 | 0.30 |
| β-bisabolene | - | - | - | 20.80 | 5.60 | 5.00 | |||
| γ-cadinene | trace | 0.80 | 0.20 | 0.40 | - | - | - | 0.20 | 0.20 |
| caryophyllene oxide | 0.30 | 0.33 | 0.90 | - | 3.68 | 1.21 | 2.00 | 0.30 | 0.20 |
| spathulenol | - | - | - | 0.30 | - | - | 2.20 | 0.60 | 0.80 |
| cubenol | - | - | trace | - | - | - | - | - | - |
| γ-muurolol | - | - | - | - | - | - | - | - | - |
| τ-cadinol | - | - | 4.20 | - | - | - | - | 0.20 | 0.30 |
| γ-terpinene | trace | - | 0.20 | 0.50 | - | - | - | 0.20 | 0.10 |
| octen-3-yl acetate | 0.03 | - | - | - | - | - | - | - | - |
| norborneol acetate | - | - | - | - | - | - | - | - | - |
| Name | Abbreviation | RI | Oil, Column and Area (%) ± SD | |||
|---|---|---|---|---|---|---|
| Literat. | Exper. | ETJA | Crimean | |||
| ZB-5HT | HP-5MS | SupelcoWAX | ||||
| tricyclene | B MO | 923 | 920 | - | 0.04 ± 0.00 | 0.01 ± 0.00 |
| α-thujene | B M | 928 | 928 | - | 0.18 ± 0.01 | 0.04 ± 0.00 |
| α-pinene | B M | 936 | 933 | 0.7 ± 0.01 | 0.36 ± 0.01 | - |
| camphene | B M | 950 | 947 | 0.31 ± 0.02 | 0.27 ± 0.01 | 0.05 ± 0.01 |
| β-phellandrene | M M | 973 | 973 | 0.09 ± 0.00 | 0.09 ± 0.01 | - |
| β-pinene | B M | 978 | 974 | 0.22 ± 0.01 | 0.11 ± 0.01 | - |
| octen-3-ol | OT | 980 | 983 | 0.04 ± 0.01 | 0.61 ± 0.01 | 0.16 ± 0.01 |
| 3-octanone | OT | 985 | 988 | - | 0.10 ± 0.01 | 0.01 ± 0.01 |
| β-myrcene | A M | 989 | 991 | 0.38 ± 0.02 | 0.25 ± 0.01 | 0.08 ± 0.00 |
| 3-carene | B M | 1011 | 1005 | 0.36 ± 0.01 | 0.86 ± 0.01 | 0.20 ± 0.01 |
| sabinene | B M | 1004 | 1009 | - | 0.02 ± 0.01 | 0.02 ± 0.01 |
| p-cymene | M M | 1024 | 1020 | 0.58 ± 0.01 | 0.22 ± 0.02 | - |
| o-cymene | M M | 1041 | 1022 | 1.03 ± 0.06 | 0.18 ± 0.00 | |
| limonene | M M | 1029 | 1026 | 19.02 ± 0.07 | 0.55 ± 0.02 | 0.15 ± 0.00 |
| eucalyptol | B MO | 1031 | 1027 | - | 5.00 ± 0.10 | 1.66 ± 0.02 |
| (E)-β-ocimene | A M | 1048 | 1040 | 0.02 ± 0.01 | 0.99 ± 0.01 | 0.44 ± 0.01 |
| (Z)-β-ocimene | A M | 1037 | 1049 | 0.75 ± 0.02 | 0.41 ± 0.01 | |
| trans-linalool oxide | A MO | 1083 | 1070 | 0.05 ± 0.01 | 0.53 ± 0.03 | 0.08 ± 0.00 |
| β-citral | A M | 1245 | 1084 | - | 0.08 ± 0.01 | - |
| cis-linalool oxide | A MO | 1075 | 1091 | 0.15 ± 0.01 | 0.52 ± 0.02 | 0.07 ± 0.01 |
| trans-sabinene hydrate | B MO | 1098 | 1097 | - | 0.10 ± 0.04 | 0.04 ± 0.00 |
| linalool | A MO | 1099 | 1105 | 41.84 ± 0.10 | 34.13 ± 0.25 | 52.71 ± 0.33 |
| cis-p-menth-2-en-1-ol | M MO | 1123 | 1116 | - | 0.01 ± 0.00 | - |
| trans-pinocarveol | B MO | 1140 | 1135 | - | 0.04 ± 0.01 | - |
| camphor | B MO | 1143 | 1141 | 0.15 ± 0.01 | 0.54 ± 0.01 | 0.09 ± 0.01 |
| myrtenol | B MO | 1150 | 1146 | 0.19 ± 0.01 | 0.08 ± 0.04 | - |
| borneol | B MO | 1166 | 1168 | - | 1.50 ± 0.01 | - |
| p-cymen-8-ol | B MO | 1184 | 1171 | - | 0.04 ± 0.01 | 0.03 ± 0.00 |
| lavandulol | A MO | 1168 | 1175 | 0.18 ± 0.01 | 0.54 ± 0.01 | 0.11 ± 0.02 |
| terpinen-4-ol | M MO | 1177 | 1181 | 0.29 ± 0.01 | 6,66 ± 0.04 | 2.29 ± 0.02 |
| sabine ketone | B MO | 1194 | 1190 | - | 0.50 ± 0.02 | 0.08 ± 0.00 |
| m-cymen-8-ol | B MO | 1180 | 1192 | 0.03 ± 0.01 | 0.16 ± 0.01 | 0.03 ± 0.00 |
| α-terpineol | M MO | 1190 | 1197 | 0.07 ± 0.00 | 1.54 ± 0.03 | - |
| hexyl butyrate | OT | 1191 | 1203 | - | 0.63 ± 0.02 | - |
| isobornyl formate | B MO | 1240 | 1230 | - | 0.13 ± 0.01 | 0.61 ± 0.01 |
| geraniol | A MO | 1255 | 1234 | 0.02 ± 0.01 | 0.08 ± 0.01 | 0.03 ± 0.01 |
| cumin aldehyde | M MO | 1238 | 1242 | - | 0.18 ± 0.00 | 0.03 ± 0.00 |
| carvone | M MO | 1242 | 1245 | 0.04 ± 0.01 | 0.05 ± 0.01 | 0.01 ± 0.00 |
| linalyl acetate | A MO | 1255 | 1259 | 32.70 ± 0.08 | 23.29 ± 0.30 | 36.56 ± 0.34 |
| α-bisabolol | M SO | 1282 | 1266 | - | 0.03 ± 0.01 | - |
| dihydrocarveol | M MO | 1194 | 1277 | - | 0.05 ± 0.07 | - |
| bornyl acetate | B MO | 1283 | 1278 | - | 0.15 ± 0.01 | 0.04 ± 0.01 |
| lavendulyl acetate | A MO | 1289 | 1285 | 0.06 ± 0.01 | 2.45 ± 0.02 | 0.51 ± 0.01 |
| verbenone | B MO | 1206 | 1296 | - | 0.04 ± 0.01 | - |
| neryl acetate | A MO | 1363 | 1359 | 0.39 ± 0.02 | 0.22 ± 0.01 | 0.05 ± 0.01 |
| β-bourbonene | B S | 1384 | 1373 | - | 0.05 ± 0.00 | 0.01 ± 0.00 |
| α-trans-bergamotene | B S | 1434 | 1382 | - | 0.17 ± 0.01 | - |
| α-cedrene | B S | 1412 | 1398 | - | 0.06 ± 0.00 | - |
| β-caryophellene | B S | 1406 | 1402 | - | 0.11 ± 0.10 | - |
| caryophyllene | B S | 1420 | 1408 | 0.5 ± 0.01 | 4.19 ± 0.10 | 1.63 ± 0.02 |
| α-santalene | B S | 1421 | 1411 | - | 1.05 ± 0.03 | 0.23 ± 0.01 |
| α-cis-bergamotene | B S | 1414 | 1429 | - | 0.28 ± 0.00 | 0.02 ± 0.00 |
| β-farnesene | A S | 1456 | 1454 | 0.1 ± 0.01 | 0.96 ± 0.01 | 0.28 ± 0.02 |
| germacene D | A S | 1481 | 1496 | - | 0.03 ± 0.02 | - |
| β-bisabolene | M S | 1508 | 1504 | - | 0,02 ± 0.01 | - |
| γ-cadinene | B S | 1513 | 1507 | - | 0.53 ± 0.01 | - |
| caryophyllene oxide | B SO | 1581 | 1572 | - | 2.59 ± 0.01 | 0.29 ± 0.00 |
| spathulenol | B SO | 1576 | 1601 | - | 0.02 ± 0.00 | - |
| cubenol | B SO | 1636 | 1603 | - | 0.04 ± 0.01 | - |
| γ-muurolol | B S | 1645 | 1622 | - | 0.02 ± 0.01 | 0.07 ± 0.00 |
| τ-cadinol | B SO | 1640 | 1628 | - | 0.25 ± 0.01 | 0.03 ± 0.01 |
| γ-terpinene | M M | 1060 | 1060 | 0.08 ± 0.01 | - | 0.02 ± 0.00 |
| octen-3-yl acetate | OT | 1110 | 1091 | - | - | 0.21 ± 0.01 |
| norborneol acetate | B MO | 1114 | 1129 | - | - | 0.08 ± 0.00 |
| α-terpinene | M M | 1017 | 1016 | 0.53 ± 0.01 | - | - |
| Not described in literature | ||||||
| m-cymene | M M | 999 | 970 | - | 0.03 ± 0.01 | - |
| butanoic acid, butyl ester | OT | 990 | 997 | - | 0.15 ± 0.01 | 0.13 ± 0.01 |
| acetic acid, hexyl ester | OT | 1004 | 1016 | - | 0.22 ± 0.00 | 0.07 ± 0.00 |
| bicyclo[3.1.0]hexan-2-ol | B MO | 1064 | - | 0.20 ± 0.01 | - | |
| isopulegone | M MO | 1157 | 1068 | - | 0.01 ± 0.00 | - |
| eucarvone | M MO | 1048 | 1077 | - | 0.01 ± 0.00 | - |
| 2-carene | B M | 1006 | 1079 | 0.02 ± 0.0 | 0.01 ± 0.01 | - |
| 6-camphenol | B MO | 1110 | 1081 | - | 0.01 ± 0.00 | - |
| cinerone | M MO | 1084 | 1088 | - | 0.04 ± 0.01 | - |
| octen-1-ol acetate | OT | 1192 | 1112 | - | 1.06 ± 0.04 | - |
| isopulegol isomer | M MO | 1146 | 1139 | - | 0.03 ± 0.01 | - |
| butanoic acid, hexyl ester | OT | 1190 | 1156 | - | 0.11 ± 0.01 | 0.02 ± 0.01 |
| Z-farnesol | A SO | 1160 | - | 0.02 ± 0.01 | - | |
| 3,7 octadiene-2,6 diol 2,6-dimethyl isomer | A MO | 1189 | 1200 | - | 0.22 ± 0.01 | 0.02 ± 0.00 |
| isopulegol isomer | M MO | 1156 | 1214 | - | 0.02 ± 0.01 | - |
| p-menthane-1,2,3-triol | M MO | 1251 | - | 0.16 ± 0.01 | - | |
| E-farnesol | A SO | 1269 | - | 0.02 ± 0.01 | - | |
| α-limonene diepoxide | M MO | 1297 | 1271 | - | 0.13 ± 0.01 | - |
| 3,7-octadiene-2,6-diol-2,6-dimethyl isomer | A MO | 1229 | 1332 | - | 0.12 ± 0.01 | - |
| hydroxy linalool | A MO | 1367 | 1345 | - | 0.15 ± 0.01 | - |
| limonene oxide | M MO | 1336 | 1348 | - | 0.15 ± 0.00 | - |
| epicubenol | B SO | 1627 | 1364 | - | 0.03 ± 0.00 | - |
| linalool formate | A MO | 1219 | 1379 | - | 0.27 ± 0.01 | - |
| nerolidyl acetate | A SO | 1687 | 1385 | - | 0.01 ± 0.00 | - |
| β-cedrene | B S | 1419 | 1439 | - | 0.09 ± 0.01 | - |
| epi-β-santalene | B S | 1431 | 1441 | - | 0.04 ± 0.01 | 0.01 ± 0.00 |
| santalol | B SO | 1617 | 1442 | - | 0.01 ± 0.00 | - |
| humulene | B S | 1455 | 1444 | - | 0.13 ± 0.01 | 0.03 ± 0.00 |
| limonen-6-ol pivalate | M SO | 1452 | - | 0.13 ± 0.01 | - | |
| β-cubenene | B S | 1527 | 1473 | - | 0.09 ± 0.00 | |
| β-carryophyllene isomer | B S | 1455 | 1479 | - | 0.10 ± 0.02 | - |
| α-santanol | B SO | 1671 | 1514 | - | 0.06 ± 0.01 | - |
| calamenene | B S | 1543 | 1515 | - | 0.03 ± 0.01 | - |
| tricyclo[7.2.0.0(2,6)]undecan-5-ol,2,6,10-tetramethyl | B SO | 1548 | - | 0.07 ± 0.01 | - | |
| zingiberene | M S | 1495 | 1495 | - | - | 0.01 ± 0.00 |
| benzeneethanol | OT | 1121 | 1120 | - | 0.06 ± 0.01 | |
| cyclofenchene | B M | 882 | 892 | 0.34 ± 0.01 | - | - |
| β-copaene | B M | 1433 | 1433 | 0.04 ± 0.01 | - | - |
| 2-bornanone | B MO | 1143 | 1136 | 0.05 ± 0.01 | - | - |
| isoborneol | B MO | 1158 | 1145 | 0.46 ± 0.01 | - | - |
| Abbreviation | Oil, Column and Area (%) | |||
|---|---|---|---|---|
| ETJA | Crimean | |||
| ZB-5HT | HP-5MS | SupelcoWAX | ||
| Aliphatic monoterpenes | A M | 0.40 | 2.07 | 0.93 |
| Monocyclic monoterpenes | M M | 20.30 | 1.92 | 0.35 |
| Bi- and tricyclic monoterpenes | B M | 1.99 | 1.81 | 0.31 |
| Monoterpenes | M | 22.69 | 5.80 | 1.59 |
| Aliphatic monoterpenoids | A MO | 75.39 | 62.52 | 90.14 |
| Monocyclic monoterpenoids | M MO | 0.40 | 9.04 | 2.33 |
| Bi- and tricyclic monoterpenoids | B MO | 0.88 | 8.53 | 2.67 |
| Monoterpenoids | MO | 76.67 | 80.09 | 95.14 |
| Aliphatic sesquiterpenes | A S | 0.10 | 0.99 | 0.28 |
| Monocyclic sesquiterpenes | M S | - | 0.02 | 0.01 |
| Bi- and tricyclic sesquiterpenes | B S | 0.50 | 6.94 | 2.00 |
| Sesquiterpenes | S | 0.60 | 7.95 | 2.29 |
| Aliphatic sesquiterpenoids | A SO | - | 0.05 | - |
| Monocyclic sesquiterpenoids | M SO | - | 0.16 | - |
| Bi- and tricyclic sesquiterpenoids | B SO | - | 3.07 | 0.32 |
| Sesquiterpenoids | SO | - | 3.28 | 0.32 |
| Others | OT | 0.04 | 2.88 | 0.66 |
| Species of Isolates | Oil Concentration (μL/cm3) | Zones of Inhibition (mm) ± SD | |
|---|---|---|---|
| ETJA | Crimean | ||
| Bacillus cereus | 40 | 47.0 ± 4.2 | 0 |
| 80 | 40.0 ± 3.5 | 19.5 ± 0.7 | |
| Bacillus subtilis | 80 | 23.5 ± 0.7 | 0 |
| Bacillus mycoides | 60 | 33.0 ± 1.4 | 0 |
| Staphylococcus warneri | 80 | 22.8 ± 0.4 | 0 |
| Micrococcus luteus | 80 | 19.0 ± 1.4 | 12.5 ± 0.7 |
| Enterococcus faecium | 80 | 0 | 0 |
| Corynebacterium spp. | 50 | 18.5 ± 0.7 | 13.0 ± 1.4 |
| Escherichia coli | 80 | 0 | 16.0 ± 1.4 |
© 2019 by the authors. Licensee MDPI, Basel, Switzerland. This article is an open access article distributed under the terms and conditions of the Creative Commons Attribution (CC BY) license (http://creativecommons.org/licenses/by/4.0/).
Share and Cite
Białoń, M.; Krzyśko-Łupicka, T.; Nowakowska-Bogdan, E.; Wieczorek, P.P. Chemical Composition of Two Different Lavender Essential Oils and Their Effect on Facial Skin Microbiota. Molecules 2019, 24, 3270. https://doi.org/10.3390/molecules24183270
Białoń M, Krzyśko-Łupicka T, Nowakowska-Bogdan E, Wieczorek PP. Chemical Composition of Two Different Lavender Essential Oils and Their Effect on Facial Skin Microbiota. Molecules. 2019; 24(18):3270. https://doi.org/10.3390/molecules24183270
Chicago/Turabian StyleBiałoń, Marietta, Teresa Krzyśko-Łupicka, Ewa Nowakowska-Bogdan, and Piotr P. Wieczorek. 2019. "Chemical Composition of Two Different Lavender Essential Oils and Their Effect on Facial Skin Microbiota" Molecules 24, no. 18: 3270. https://doi.org/10.3390/molecules24183270
APA StyleBiałoń, M., Krzyśko-Łupicka, T., Nowakowska-Bogdan, E., & Wieczorek, P. P. (2019). Chemical Composition of Two Different Lavender Essential Oils and Their Effect on Facial Skin Microbiota. Molecules, 24(18), 3270. https://doi.org/10.3390/molecules24183270








